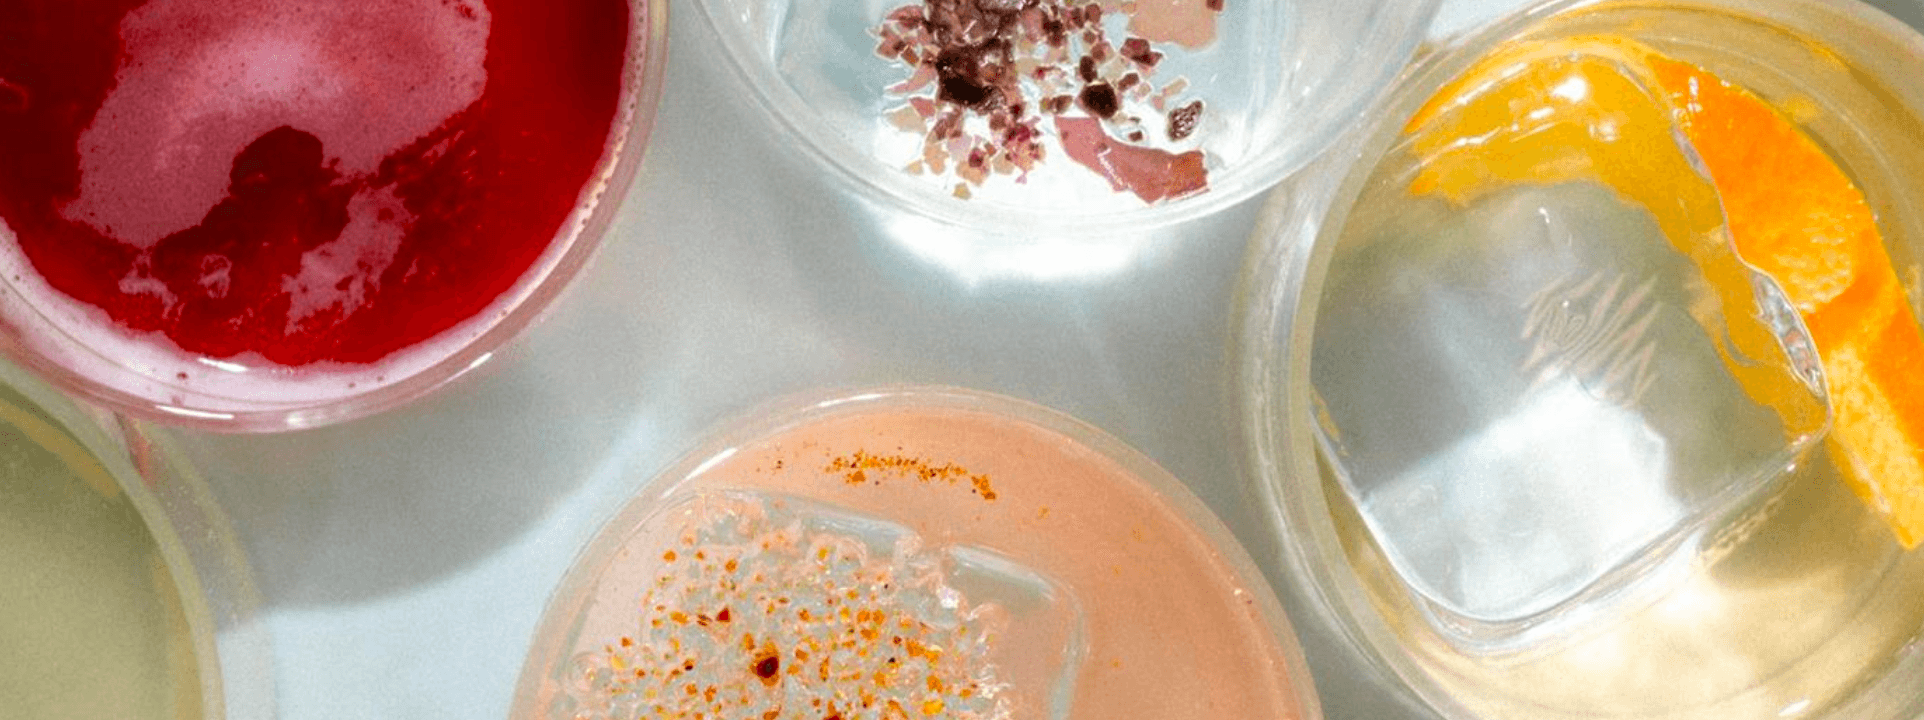
Empirical, a flavour company

MEANING FORMS .STORY CONNECTS .CONTENT FLOWS .
意义在流动中成形 .叙事穿行 .内容触达 .
πάντα ῥεῖ ·
Everything flows
— attributed to Heraclitus.
Pink is the colour of the cerebral cortex — the temperature of an idea before it cools. Tides rise and fall to their own rhythm. Pink Fluid believes that truth and meaning are caught in motion.
Brand narrative, curation, spatial content, digital communications — the dimensions change, the method doesn't. Whatever the project, we start with narrative. Before the floor plan. Before the visual proposal. Before anything visible takes shape. We work with architects, spatial designers, exhibition designers, and digital strategists, assembling each team around the brief.
We built a complete narrative system for a Yunnan organic tea brand — from strategy to a spatial exhibition inside their new facility. First visit to the mountain: 2018. Formal collaboration: 2025. Project ongoing. We curated Jacky Tsai's 1,800 sqm solo retrospective at Shenzhen's Museum of Contemporary Art and Urban Planning, then delivered something entirely different for his work in a commercial space on Shanghai's West Bund. We styled a private collector's lakeside villa in Kunming from concept to the last teacup — published in AD China, 2020. And we brought Empirical and Mezcal Verde into the Chinese market, building brand strategy and content for two spirits brands that refuse easy categories.
If your work involves space — a heritage hotel ready to be perceived differently, a new boutique property looking for its cultural identity, a tourism project searching for a real connection to its place — I start as a guest. I experience the architecture, the history, the present, the people. Then we work from strategy through to delivery.
If you are a brand founder, we begin with an interview, backed by serious desk research. No rush to a proposal. Most founders already have the answer — it just hasn't been shaped into a strategy. Our first move is turning scattered instincts into one clear narrative line.
If you are an artist who needs more exhibitions, sharper audiences, strategic visibility, and a route from artistic value into commercial partnership — we start from your practice and build outward. Exhibition planning, brand collaborations, media. So the value of what you make travels further than the work itself.
Starting points differ. Dimensions differ. One thread throughout: reveal meaning, construct narrative, create content.

Rosalind Jing JIN spent nearly a decade in the City of London, working in debt capital markets at Dresdner Kleinwort, Commerzbank, and Crédit Agricole CIB, covering sovereign, supranational, and public sector clients.
After returning to China in 2014, she spent close to six years in Yunnan. She oversaw the renovation and pre-opening of Silver Chest, Kunming's first heritage-building boutique hotel, as the investor's representative, then co-founded Puform Architecture (now Suzao Architecture) as managing partner — responsible for client relations, business development, branding, and financial management. In 2020, she co-founded consumer brand Moli & Pals in Guangzhou, leading brand identity, marketing strategy, e-commerce operations, and supply chain management.
Since 2021, Rosalind has focused on curatorial practice in contemporary art, design, and architecture, alongside narrative strategy and commercialisation for brands. Pink Fluid is her current independent practice.
Rosalind holds a Bachelor's in Economics from Zhejiang University and a Master's in International Finance from the University of Amsterdam. She is based in Shanghai.